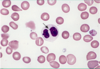

Haem: Myelodysplastic syndromes and Aplastic anaemia Flashcards
Define myelodysplastic syndrome.
Heterogenous group of acquired stem cell disorders with ineffective haematopeoisis –> defects in maturation of all myeloid cells
(hypercellular bone marrow with dysplastic cells –> pancytopaenia)
by definition will have <20% blasts
What are the key characteristics of myelodysplastic syndromes?
- Development of a clone of marrow stem cell with abnormal maturation resulting in functionally defective blood cells and a reduction in cell counts
- This leads to pancytopaenia, functional abnormalities of cell maturation and an increased risk of transformation to leukaemia
pancytopaenia = anaemia, thrombocytopenia, leukopenia
Which types of patients tend to develop myelodysplastic syndromes?
Elderly
How do myelodysplastic syndromes typically present?
Symptoms/signs of bone marrow failure developing over weeks/months
List and describe some blood and bone marrow features of myelodysplastic syndromes.
- BM failure and cytopenias –> infection, bleeding, fatigue.
- Hypercellular BM.
- Defective cells:
o RBCs e.g. ringed sideroblasts (abnormal nucleated blast surrounded by iron granule ring), basophilic stippling
o WBCs – hypogranulation, pseudo-Pelger-Huët anomaly (bilobed neutrophils)
o Platelets – micromegakaryocytes, hypolobated nuclei.
myeloid blasts <20% in BM but >5%
What does this image show?

Pelger-Huet anomaly
What does this image show?

Refractury anaemia dysgranulopoiesis (failure of neutrophil granulation)

What does this image show?

Refractory anaemia-dyserythropoiesis of red blood cells (lack of separation between red cell precursors, presence of abnormal ring of cytoplasm around the nucleus of precursor red cells)

What does this image show?

Ringed sideroblast (accumulation of iron around the nuclei of red blood cell precursors)
iron is in mitochondria

What might you see if you stained for iron in the bone marrow of a patient with a myelodysplastic syndrome?
Ringed sideroblasts (accumulation of iron around the nuclei of red blood cell precursors)

What is purpose of MDS treatment
to prevent progression to AML
What is the presence of myeloblasts with Auer rods suggestive of?
Acute myeloid leukaemia.

List some factors that are taken into account when classifying types of myelodysplastic syndrome.
- Cell lineage affected
- Blast cell proportions
- Cytogenetics
- Presence of ringed sideroblasts
- Cytopaenia
What are the five prognostic variables that are used to calculate prognostic risk using the Revised International Prognostic Scoring System (IPSS-R) for Myelodysplastic Syndromes?
- Bone marrow blast percentage
- Karyotype
- Haemoglobin
- Platelet count
- Neutrophil count
NOTE: high risk is considered a score > 6, low risk ≤ 1.5
How does myelodysplasia tend to evolve from the time of diagnosis?
Blood counts will decrease (leading to worsening bone marrow failure)
Some patients will develop acute myeloid leukaemia (poor prognosis)
What are the usual causes of death in patients with myelodysplasia?
- 1/3 infection
- 1/3 bleeding
- 1/3 leukaemia
What are the two treatments that can prolong life in myelodysplastic syndromes?
- Allogeneic stem cell transplantation
- Intensive chemotherapy
NOTE: as most MDS patients are elderly, they often cannot tolerate treatment
List some other treatments that may be used in myelodysplastic syndromes.
- Supportive Care (blood products, antimicrobials, growth factors (e.g. EPO, GM-CSF)
- Biological modifiers
- Immunosuppression
- Azacytidine (hypomethylating agent)
- Decitabine
- Lenalidomide (used in 5q minus syndrome)
- Oral chemotherapy (e.g. hydroxyurea)
- Low-dose chemotherapy (SC low-dose cytarabine)
List some causes of primary bone marrow failure.
Acquired
* Idiopathic aplastic anaemia (multipotent stem cell)
Inherited
* Fanconi anaemia (multipotent stem cell)
* Diamond-Blackfan syndrome (red cell progenitor)
* Kostmann syndrome (neutrophil progenitor)
List some secondary causes of bone marrow failure.
- Marrow infiltration
- Haematological malignancies
- Solid tumours spreading to bone marrow
- - Radiation
- Drugs
- Chemicals (e.g. benzene)
- - Autoimmune
- Infection (e.g. parvovirus B19)
List some drugs that can cause bone marrow failure.
- Cytotoxic drugs (predicatble, dose-dependent)
- Phenylbutazone, Gold salts (idiosyncratic, rare)
- Antibiotics - chloramphenicol, sulphonamides
- Diuretics - thiazide
- Antithyroid drugs - carbimazole
Which age groups are affected by aplastic anaemia?
- All age groups (mainly 15-24 and 60+)
NOTE: this is much more rare than MDS
What is the most common cause of aplastic anaemia?
Idiopathic (70-80%)
List some inherited causes of aplastic anaemia.
- Fanconi anaemia
- Schwachman-Diamond syndrome
- Dyskeratosis Congenita
Outline the possible pathophysiology of idiopathic aplastic anaemia.
- Characterised by failure of the bone marrow to produce blood cells
- Either due to an inherent issue with the stem cells or due to autoimmune attack on stem cells
What are some investigative features of aplastic anaemia?
- Peripheral blood - pancytopaenia - low RBC, low WBC, low platelets
- Bone marrow - hypocellular
How can aplastic anaemia be classified?
Severe or non-severe
List some differential diagnosis for pancytopaenia and hypocellular marrow.
- Hypoplastic MDS/AML
- Hypocellular ALL
- Hair cll leukaemia
- Atypical mycobacterial infection
- Anorexia nervosa
- ITP (although Hb and RBC will be normal)
What is the Camitta criteria for severe aplastic anaemia?
2 out of 3 peripheral blood features:
- Reticulocytes < 1% (< 20 x 109/L)
- Neutrophils < 0.5 x 109/L
- Platelets < 20 x 109/L
Bone marrow cellularity < 25%
Outline the management approaches used for bone marrow failure.
- Seek and remove cause
- Supportive (blood products, antibiotics, iron chelation)
- Immunosuppressive therapy (anti-thymocyte globulin, steroids, ciclosporin A)
- Drugs that promote bone marrow recovery (oxymetholone (androgen), thrombopoietin receptor agonist (eltrombopag))
- Stem cell transplantation
- Alemtuzumab (T cell depletion) - for refractory cases
How might the age of the patient influence decisions regardint their management?
- Immunosuppressive therapies tend to be used in older patients
- SCT tends to be used in younger patients (80% cure rate)
List some late complications that occur after immunosuppressive therapy for aplastic anaemia.
- Relapse (35% in 15 years)
- Clonal haematological disorders - 20% risk in 10 years (myelodysplasia, leukaemia, paroxysmal nocturnal haemoglobinuria)
- Solid tumours (3% risk)
What is the most common cause of inherited aplastic anaemia?
Fanconi anaemia
What is the inheritance pattern of Fanconi anaemia?
Autosomal Recessive or X-linked Recessive
What do the gene mutations implicated in Fanconi anaemia tend to result in?
- Abnormalities in DNA repair
- Chromosomal fragility (breakage in the presence of in vitro mitomycin and diepoxybutane)
List some somatic abnormalities that are seen in Fanconi anaemia.
- Short stature
- Hypopigmented spots/café-au-lait spots
- Abnormality of thumbs
- Microcephaly or hydrocephaly
- Hypogonadism
- Developmental delay
NOTE: these are only present in 70% of patients
List some complications of Fanconi anaemia.
- Aplastic anaemia (90%)
- Myelodysplasia
- Leukaemia
- Cancer (epithelial)
- Liver disease
What are the characteristic features of dyskeratosis congenita?
- Bone marrow failure
- Cancer predisposition
- Somatic abnormalities
What are the three main somatic features of dyskeratosis congenita?
- Abnormal skin pigmentation
- Nail dystrophy
- Leukoplakia
Which genes are involved in dyskeratosis congenita and what are the inheritance patterns?
- X-linked recessive (MOST COMMON) - DKC1 gene (defective telomere functioning)
- Autosomal dominant - TERC (RNA components of telomerase)
- Autosomal recessive - no mutation identified
NOTE: abnormal telomeric structure and function is heavily implicated in dyskeratosis congenita
What are telomeres and what are their main functions?
- Found at the end of chromosomes
- Prevent chromosomal fusion or rearrangements during chromosomal replication
- Protect genes at the end of chromosomes from degradation
NOTE: telomere length is reduced in bone marrow failure diseases (and they are especially short in dyskeratosis congenita)